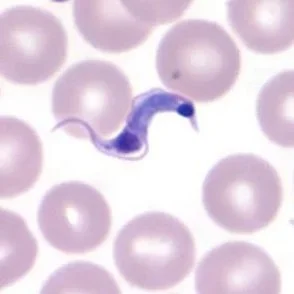

Caused by the protozoan parasite Trypanosoma cruzi, Chagas Disease is endemic to every country in the Americas besides Canada. It affects an estimated 10 million people worldwide, causing 8-12,000 annual deaths and $7.2 billion in annual economic losses.
T. cruzi is primarily spread through the excrement of triatomine bugs, and can also be ingested via contaminated food or water. Of note, the parasite may be passed vertically during gestation, leading to new cases in non-endemic countries due to immigration.
Chronic infection with T. cruzi can lead to megaesophagus or megacolon in 10-20% of people, and to chronic Chagas cardiomyopathy (CCC) in 20-40% of people. Patients with CCC have a higher rate of stroke, heart attack, and sudden cardiac death when compared to cardiac disease of other etiologies, and 90% of CCC patients will die due to Chagas-related complications.
Chagas Disease is a major cause of non-ischemic cardiomyopathy, heart transplantation, and cardiac death in the Americas.
Chagas Disease is currently under-diagnosed, under-treated, and under-reported.
We need a strong workforce of cardiologists to improve and support patient care and clinical management of chronic Chagas cardiomyopathy. Help us towards a world with proper CCC surveillance, treatment and control! Be a part of the effort by learning about the most recent research and advances in CCC treatment and care at the first annual CCC conference.